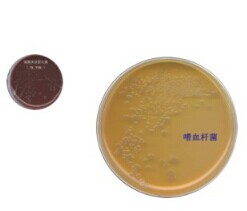
产品封面图

万千商家帮你免费找货
0 人在求购买到急需产品
- 详细信息
- 文献和实验
- 技术资料
- 保质期:
电询
- 英文名:
电询
- 库存:
100
- 供应商:
上海古朵生物科技有限公司
- 保存条件:
电询
致病性大肠艾希氏菌血清15种 编号:GD-TR301 品名:致病性大肠艾希氏菌血清15种 单位:盒 规格:1ml*18,致病性大肠艾希氏菌血清15种欢迎新老客户来电详谈!
购买我公司的致病性大肠艾希氏菌血清15种 ,价格优惠,质量可靠,实验效果好,公司对每个产品的质量都严格要求以确保每个产品质量合格,让顾客买的放心,用的安心,上海古朵期待与您的合作!
本公司所有产品主要用于科研方面,不用于临床诊断。
致病性大肠艾希氏菌血清15种 相关产品:
GD-TR503 伤寒、副伤寒及变形杆菌诊断菌液 盒 10ml*8
GD-TR402 O1群0139霍乱弧菌多价诊断血清 瓶 1ml×1瓶
GD-TR303 产毒性大肠艾希氏菌诊断血清 盒 1ml×10瓶
GD-K2021 羊血(血浆袋包装) 袋 25ml
GD-K2022 羊血(血浆袋包装) 袋 50ml
GD-K2023 羊血(白蛋白包装) 瓶 50ml
编号 品名 单位 规格
GD-TR301 致病性大肠艾希氏菌血清15种 盒 1ml*18
风险提示:丁香通仅作为第三方平台,为商家信息发布提供平台空间。用户咨询产品时请注意保护个人信息及财产安全,合理判断,谨慎选购商品,商家和用户对交易行为负责。对于医疗器械类产品,请先查证核实企业经营资质和医疗器械产品注册证情况。
文献和实验肠埃希氏菌(E. coli)通常称为大肠杆菌,是Escherich在1885年发现的,在相当长的一段时间内,一直被当作正常肠道菌群的组成部分,认为是非致病菌。直到20世纪中叶,才认识到一些特殊血清型的大肠杆菌对人和动物有病原性医学教育|网搜集整理,尤其对婴儿和幼畜(禽),常引起严重腹泻和败血症,它是一种普通的原核生物,根据不同的生物学特性将致病性大肠杆菌分为5类:致病性大肠杆菌(EPEC)、肠产毒性大肠杆菌(ETEC)、肠侵袭性大肠杆菌(EIEC)、肠出血性大肠杆菌(EHEC)、肠黏附
,2a,2b,3a,3b,4a,4b,4c,5a,5b - + + + (1)A群:又称痢疾志贺氏菌(Sh.dysenteriae),通称志贺氏痢疾杆菌。不发酵甘露醇。有12个血清型,其中8型又分为三个亚型。 (2)B群:又称福氏志贺氏菌(Sh.flexneri),通称福氏痢疾杆菌。发酵甘露醇。有15个血清型(含亚型及变种),抗原构造复杂,有群抗原和型抗原。根据型抗原的不同,分为6型,又根据群抗原的不同将型分为亚型;X、Y变种没有特异性抗原,仅有不同的群抗原
培养基、糖发酵管、ONPG培养基、半固体琼脂、丙二酸钠培养基、沙门氏菌因子血清:按26种用于初步分型;57种用于进一步分型;163种用于详细分型。4 检验程序沙门氏菌检验程序如下:5 操作步骤5.1 前增菌取检样25g,加入225mL缓冲蛋白胨水于均质杯内。用均质器以8000~10000r/min打碎1min,于36±1℃培养4h(干蛋品培养18~24h),移取10mL,转种于100mL氯化镁孔雀绿增菌液(MM)或四硫酸钠煌绿(TTB)增菌液内,于42℃培养18~24h。同时,另取10mL,转种
技术资料暂无技术资料 索取技术资料